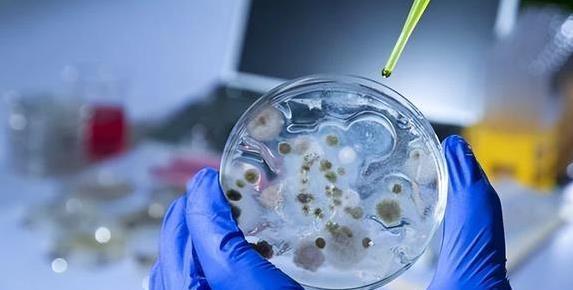

冰层融化,古老病毒醒了!全球变暖让北极和南极的冰川像雪糕一样化开,藏在冰里的古老病毒开始跑出来。这些病毒可不是小角色,随时可能给人类和动物带来大麻烦。它们在冰里睡了几千年,现在被放出来,世界会变成啥样?
这些病毒为啥这么吓人?科学家说,它们藏在极地的冰层里,跟着冰一起被冻住。全球气温升高,冰化得快,病毒就跟着水流到海洋里。它们特别会“搞乱”,能感染海洋里的小生物,比如浮游动物,直接把食物链搅得一团糟。
海洋可是地球的大厨房。食物链一乱,鱼、虾这些海鲜就可能越来越少。全球好多地方靠海吃饭,渔民的日子不好过了,饭桌上的海鲜也可能变少。这可不是小事,影响到每个人嘴里的饭菜。
这些病毒还很“聪明”。它们不只搞乱海洋,还能感染细菌、动物,甚至可能威胁人类。科学家发现,这些病毒能偷偷改细菌的基因,让自己更强。抗生素对它们可能没啥用,这让医生头疼,未来治病可能更难。
想当年,俄罗斯西伯利亚挖出个叫“金刚病毒”的家伙。这病毒比普通病毒大,基因也多。虽然现在对人没啥危害,但谁知道下一个醒来的病毒会不会更凶?冰层还在化,更多病毒可能在排队等着出来。
气候变暖不只是让病毒跑出来,还让极地的动物和植物日子不好过。北极熊、企鹅这些家伙,靠冰和冷水生活。冰没了,它们的家就没了。病毒再一闹,生态系统就更乱,物种可能越来越少。
人类自己也往极地跑得更多。气温高了,渔船、旅游船都往北极、南极钻。船多了,人多了,病毒传播的机会也多了。一个人不小心把病毒带到城市,后果想想都可怕。
科学家们可没闲着。他们在极地建监测站,盯着冰层下的动静。研究病毒的基因,搞清楚它们咋传播,咋感染。这就像给病毒画个“通缉令”,方便找到对付它们的办法。
保护极地不是小事。极地的冰川和海洋像地球的空调,帮着调节气温。冰化了,不只病毒出来,碳也跑出来,地球会更热。救极地就是救地球,救咱们自己。
咋救?少开车,多用绿色能源,减少废气排放。国家之间得一块儿努力,分享信息,研究对策。就像邻里街坊一起修水管,单打独斗可不行。中国在这方面没少出力,建了北极科考站,还跟其他国家合作研究气候变化。
这些病毒虽然吓人,但也有好的一面。科学家发现,它们的基因能帮着研究新药。说不定未来能靠这些病毒治大病,开发新疗法。这就像从坏事里找出好机会,化危机为转机。